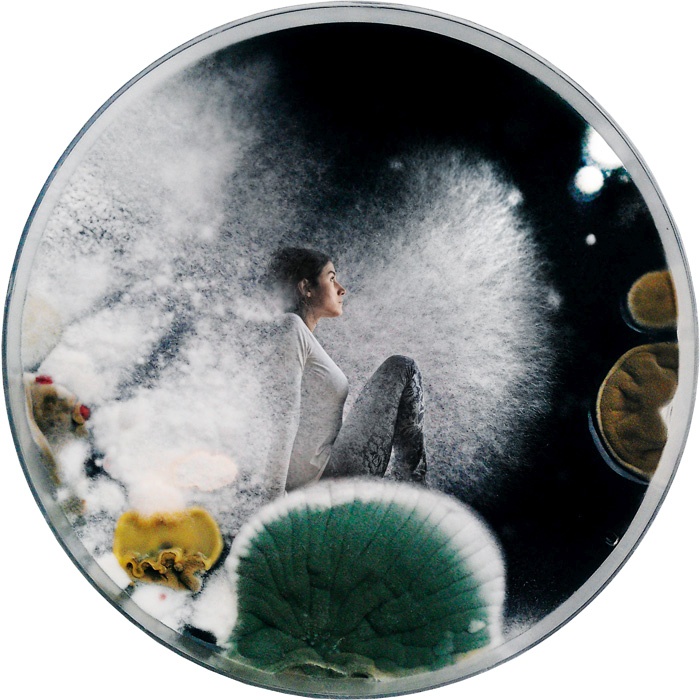

Portret / Saša Spačal, intermedijska umetnica
… ki je lani prejela častno omembo na festivalu Ars Electronica
Petra Tihole | Uroš Abram
MLADINA, št. 4, 29. 1. 2016
Je raziskovalka živih sistemov. Ena od izjemnih slovenskih bioumetnic, poleg Polone Tratnik, Špele Petrič, Robertine Šebjanič in Maje Smrekar. Ta jo je tudi spodbudila, da je pred pol desetletja v Kiberpipinem labu realizirala svoje prvo umetniško delo s področja bioumetnosti 7K: nova oblika življenja. »Takrat je bila nanotehnologija ‘buzz word’, češ da bo rešila svet,« se spomni. Navdušena nad fotografijami mikroogranizmov je sklenila, da bi to dvoje – nanotehnologija in mikroorganizmi – lahko komuniciralo. Tako je nastala interaktivna avdiovizualna umetniška instalacija, kjer se obiskovalci potopijo v poseben tehnološki ekosistem. Svet, naseljen z rastlinjem, mikroskopskimi organizmi in posebno vrsto skonstruiranih nanobitij – robotkov.
Petra Tihole | Uroš Abram
MLADINA, št. 4, 29. 1. 2016
Je raziskovalka živih sistemov. Ena od izjemnih slovenskih bioumetnic, poleg Polone Tratnik, Špele Petrič, Robertine Šebjanič in Maje Smrekar. Ta jo je tudi spodbudila, da je pred pol desetletja v Kiberpipinem labu realizirala svoje prvo umetniško delo s področja bioumetnosti 7K: nova oblika življenja. »Takrat je bila nanotehnologija ‘buzz word’, češ da bo rešila svet,« se spomni. Navdušena nad fotografijami mikroogranizmov je sklenila, da bi to dvoje – nanotehnologija in mikroorganizmi – lahko komuniciralo. Tako je nastala interaktivna avdiovizualna umetniška instalacija, kjer se obiskovalci potopijo v poseben tehnološki ekosistem. Svet, naseljen z rastlinjem, mikroskopskimi organizmi in posebno vrsto skonstruiranih nanobitij – robotkov.
Že vrsto let raziskuje povezave med tehnološkimi in biološkimi organizmi. Tudi z zadnjim projektom Syncness, ki je te dni na ogled v ljubljanski galeriji Kapelica, kjer se lahko oglasite na klepetu s črički. Zanimalo jo je namreč, ali je komunikacija med različnimi vrstami, denimo s pomočjo tehnologije in algoritmov, sploh mogoča. Z željo, da bi nekoč nemara res razvili jezik, ki bi nam omogočal komunicirati s črički, je v galeriji postavila instalacijo, v kateri je naselila tristo čričkov vrste Acheta domesticus. Poskrbela je, da so zavarovani pred svetlobo, pa tudi, da so na toplem. Topleje ko jim je, višja je namreč frekvenca njihovega oglašanja.
Pri odločanju, kako pristopiti h komunikaciji s črički, se seveda pojavi zadrega. Lahko recimo tudi sami »začričkamo«. Ker se oglašajo z drgnjenjem zgornjih delov krilc drugo ob drugo, morda pridamo še kak gib. Če potem pride do ujemanja zvočnih izmenjav, do dvosmerne komunikacije, se na projekcijski površini izrišejo podobe. Z mikrofoni ujeti glasovi čričkov in obiskovalcev se z zapletenim avdiovizualnim vmesnikom programerja Slavka Glamočanina namreč pretvarjajo v nekakšno abstraktno vizualizacijo. Signal o uspelem stiku pa nato prek oddajnika potuje tudi v vesolje.
Marsikaj jo zanima. Vsako človeško telo je denimo naseljeno s kar dvema kilogramoma mikrobiomov, skupkom arhej, gliv in bakterij. Zato je v projektu Mycophone_unison s pomočjo svojega telesa raziskovala simbiozo med našimi telesi in mikrobiomi. Pravzaprav so svoja telesa prispevali vsi trije soavtorji projekta in s tem so sonificirali komuniciranje med tremi mikrobiomi. In s tem odprli tudi vprašanje mej našega telesa in predvsem antropocentirčnega gledanja nanj.
V projektu Myconnect, ki ga soustvarjata Mirjan Švagelj in Anil Podgornik, pa so jo pritegnili miceliji. Ti so kot vegetativni del fungusa, ki naj bi bil eden izmed najbolj razširjenih organizmov na planetu, prisotni v talni sestavi gozdov, travnikov ... imajo pa tudi primeren električni upor, in prav s tem so jo najbolj navdihnili. Nastala je umetniška instalacija v obliki nekakšnega kokona, ki ščiti telo pred zunanjimi dražljaji. Obiskovalec se v njej uleže in njegov živčni sistem se prek njegovega srčnega utripa vpne v povratno zanko človek-vmesnik-micelij. Ta dialog sproži zvočne in svetlobne učinke, ki pa ne vplivajo tudi na vse preostale navzoče v prostoru. Projekt ji je lani prinesel častno omembo na enem najpomembnejših festivalov za umetnost tehnologijo in družbo, Ars Electronica v Linzu. To pa ji je odprlo številna vrata.
Pravzaprav se vsak njen projekt začne s fascinacijo. Z nečim, kar jo popolnoma prevzame. V procesu raziskovanja potem sodeluje z različnimi strokovnjaki, znanstveniki, s katerimi prek dialoga poglablja svoje znanje, potem pa vse skupaj sama zapelje in razširi v polje umetniškega. Pogosto se ji zgodi, da smeri, v katero se sama nagiba, znanost še ni raziskala, kar pa ne pomeni, da je tja ne vleče.
Razstavlja po vsem svetu. To pomeni, da tudi veliko potuje. Ne le kot bioumetnica, tudi kot članica eksperimentalne hrupne zasedbe Theremidi Orchestra. Se pa tudi samostojno ukvarja z glasbo. Pod imenom agapea je lani pri založbi Kamizdat Luke Prinčiča, ki jo je tudi spodbudil k prvi samostojni izdaji, objavila plošček, naslovljen 2311. Tri elektroakustične kompozicije vsebujejo zvoke njenega dihanja, srčnega utripa in nekaterih drugih organskih procesov, pa tudi terenske posnetke, na katerih lahko slišimo denimo ptice, čričke, škržate ...
Je prava umetnica v ekvilibristiki, uravnotežena, v simbiozi z vesoljem, katerega del je. Formalno je študirala sociologijo kulture in japonologijo, a nenehno se izpopolnjuje tudi na drugih področjih, tudi na »naredi-sam« delavnicah doma in v tujini. Znanje pa tudi predaja naprej, in sicer v okviru Iniciative za ženske s čutom za znanost, tehnologijo in umetnost – ČIPke, katere soustanoviteljica je ob Idi Hiršenfelder. Letos so jih zavoljo dvoumnega imena povabili tudi na svetovni čipkarski kongres, ki bo junija v Ljubljani. Še dobro, kajti tudi same so se začele spogledovati z idejo, da bi se lotile izdelovanja elektronskih čipk.